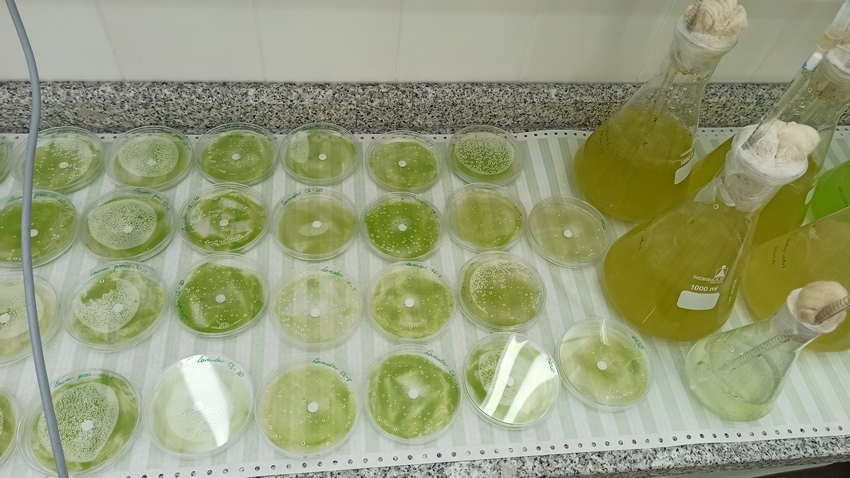
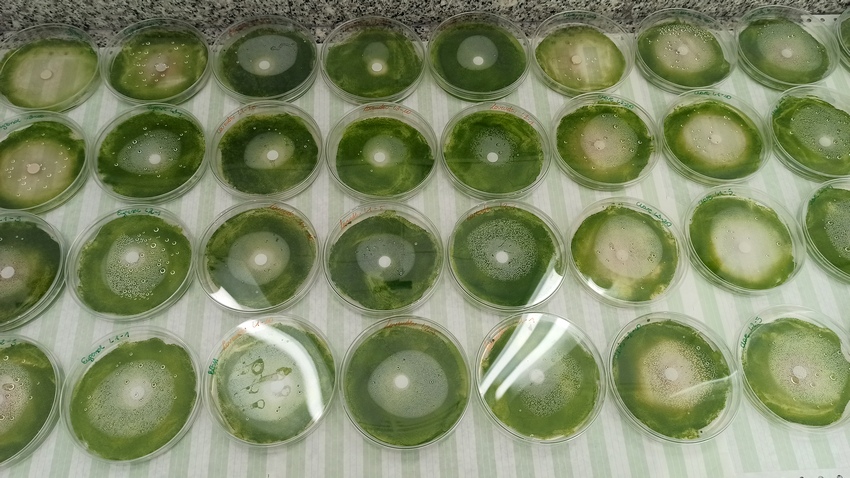
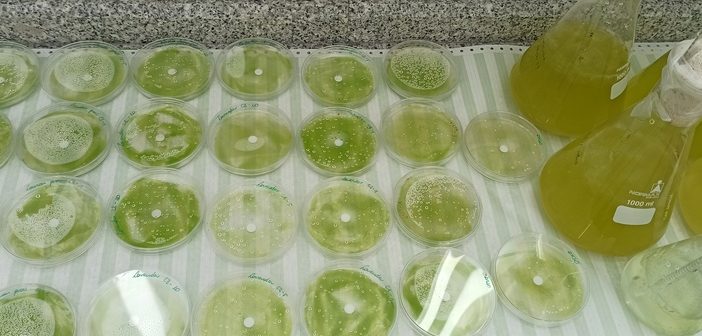

Um grupo de investigadores da Faculdade de Ciências e Tecnologia da Universidade de Coimbra (FCTUC), em colaboração com Michal Komar, estudante da Lodz University of Technology, estão a testar os efeitos da aplicação de vários óleos essenciais para eliminar e prevenir o crescimento de microalgas terrestres, frequentemente, encontradas em fachadas de edifícios e monumentos.

Até ao momento, Michal Komar, a realizar Erasmus no Departamento de Ciências da Vida (DCV) da FCTUC, já testou sete substâncias diferentes, nomeadamente cinco óleos essenciais e dois compostos ativos puros contra biofilme verde, principalmente constituído por microalgas terrestres.
Esta investigação, intitulada “Biodeterioration of building materials by aerophytic algae”, «pretende desenvolver metodologias que possam ser aplicadas para prevenir o crescimento e eliminar organismos de bio deterioração em fachadas monumentais, utilizando substâncias ecologicamente seguras», explica o estudante.
De acordo com Nuno Mesquita, investigador do DCV e orientador do aluno polaco durante a sua estadia em Coimbra, as microalgas terrestres, além de provocarem danos estéticos e até estruturais nos monumentos, devido ao crescimento por vezes endolítico, podem ainda servir de suporte e alimento para outros organismos, como por exemplo os microfungos.
«A criação de biofilmes promove o estabelecimento de diversas comunidades de outros organismos, como microfungos, que posteriormente danificam os edifícios de forma grave, causando danos físicos e até químicos. As algas são colonizadores primários, o que significa que se prevenirmos o seu crescimento ou as eliminarmos, conseguimos prevenir colonizações subsequentes e assim evitar a deterioração dos monumentos/edifícios», acredita o investigador.

Neste sentido, «foram realizados vários testes com diferentes óleos essenciais, em placas de cultura e em amostras de materiais como tijolos vermelhos (constituídos por argila, carbonato de cálcio e areia). Os biofilmes formados e tratados serão submetidos à análise do seu perfil metabolómico, para avaliar as diferentes respostas a esses fatores de stress, em termos de presença e abundância de compostos orgânicos», esclarece Michal Komar.
«Os resultados obtidos são promissores e surpreendentes. Curiosamente, nem todos os óleos utilizados que impedem o crescimento das algas são os mesmo que permitem a sua eliminação. O próximo passo é repetir estes testes diretamente em diferentes tipos de pedra», concluem.